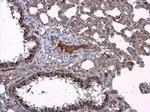
Presenilin 1 Antibody in Immunohistochemistry (Paraffin) (IHC (P))

Search
Invitrogen
Presenilin 1 Polyclonal Antibody
{{$productOrderCtrl.translations['antibody.pdp.commerceCard.promotion.promotions']}}
{{$productOrderCtrl.translations['antibody.pdp.commerceCard.promotion.viewpromo']}}
{{$productOrderCtrl.translations['antibody.pdp.commerceCard.promotion.promocode']}}: {{promo.promoCode}} {{promo.promoTitle}} {{promo.promoDescription}}. {{$productOrderCtrl.translations['antibody.pdp.commerceCard.promotion.learnmore']}}
图: 1 / 9
Presenilin 1 Antibody (PA5-85118) in ICC/IF

产品信息
PA5-85118
宿主/亚型
分类
类型
抗原
偶联物
形式
浓度
保存条件
运输条件
RRID
产品详细信息
Keep as concentrated solution.
Predicted reactivity: Mouse (86%), Rat (85%), Dog (86%), Pig (84%), Rhesus Monkey (100%).
Positive Control: 293T, A431, Jurkat, Raji, NIH-3T3.
Store product as a concentrated solution. Centrifuge briefly prior to opening the vial.
靶标信息
Presenilin1 was initially identified a marker of susceptibility to early-onset Alzheimer's disease. In addition to PEN2, nicastrin and APH-1, Presenilin1 forms the -gamma-secretase protein complex, a membrane-bound aspartyl protease that can cleave certain proteins at peptide bonds buried within the hydrophobic environment of the lipid bilayer. This cleavage is responsible for a key step in signaling from several cell-surface receptors and is thought to be required for the generation of the neurotoxic amyloid peptides that are central to the pathogenesis of Alzheimer's disease. Like the tumor necrosis factor-alpha-converting enzyme (TACE) and the beta-site cleavage enzyme (BACE) protease families, -gamma-secretase will cleave the amyloid precursor protein (APP), but within the intramembrane region of APP, resulting in either the non-toxic p3 (from the alpha and -gamma cleavage site) or the toxic Abeta amyloid peptide (from the beta and -gamma cleavage site). It is thought that accumulation of the Abeta peptide is the precursor to Alzheimer's disease. Multiple isoforms of presenilin1 are known to exist.
⚠WARNING: This product can expose you to chemicals including mercury, which is known to the State of California to cause birth defects or other reproductive harm. For more information go to www.P65Warnings.ca.gov.
仅用于科研。不用于诊断过程。未经明确授权不得转售。



